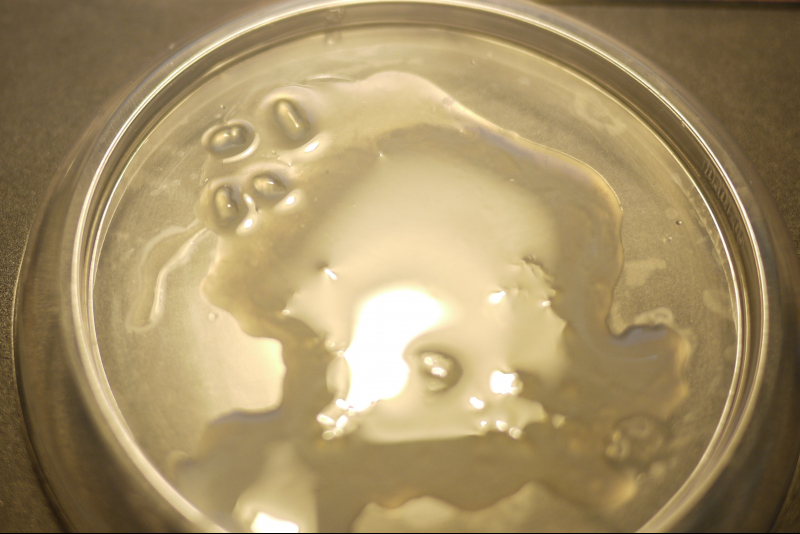

Сперма — важный показатель мужского здоровья, а её консистенция отражает состояние репродуктивной системы. Изменение цвета и текстуры, особенно прозрачность и жидкость, может указывать на физиологические и патологические процессы. В этой статье рассмотрим причины, по которым сперма становится прозрачной и жидкой, а также возможные заболевания, связанные с этими изменениями. Понимание этих аспектов поможет мужчинам обратить внимание на здоровье и при необходимости обратиться за медицинской помощью.
Временные изменения консистенции спермы
Сперма здорового мужчины имеет мутный цвет, который может колебаться от серовато-желтого до насыщенно-белого. Консистенция может быть как вязкой, так и умеренно текучей. Эякулят состоит из сперматозоидов и семенной жидкости. Любые отклонения в цвете или консистенции спермы могут сигнализировать о наличии патологий в репродуктивной системе мужчины. Одним из самых безобидных факторов, влияющих на цвет семени, является образ жизни.
Непатологические причины прозрачной спермы:
- Недостаток белковой пищи. Растительная диета содержит мало незаменимых аминокислот, которые организм не может синтезировать самостоятельно. При нехватке животного белка в рационе сперма может обесцвечиваться, особенно если мужчина активно занимается сексом.
- Кратковременные воспалительные процессы, вызванные травмами. Они являются одной из основных причин появления прозрачной спермы у мужчин.
- Чрезмерное употребление алкоголя. Алкогольное отравление может временно нарушить выработку сперматозоидов.
- Побочные эффекты от медикаментов. Некоторые лекарства могут с небольшой вероятностью оказать влияние на цвет спермы.
- Наркомания. Это негативно сказывается на эндокринной и репродуктивной системах.
В редких случаях полностью прозрачная сперма может быть единичным явлением. Чаще всего проблема может быть связана с скрытым развитием патологии. Сперматозоиды восстанавливаются в течение 24 дней. Если прозрачная сперма наблюдается не более трех дней, поводов для беспокойства нет. Однако, если это состояние продолжается дольше, стоит заподозрить наличие заболевания.
Медицинские препараты (лекарства, витамины, БАД) упоминаются только для ознакомления. Мы настоятельно рекомендуем не использовать их без назначения врача. Рекомендуем ознакомиться с материалом: «Почему нельзя принимать медицинские препараты без назначения врача?».
Врачи отмечают, что изменение консистенции спермы на более жидкую и прозрачную может быть связано с несколькими факторами. Одной из основных причин является изменение уровня гормонов, особенно тестостерона, который играет ключевую роль в производстве спермы. Также на качество семенной жидкости могут влиять стресс, неправильное питание и недостаток физической активности. Некоторые инфекции или воспалительные процессы в половой системе могут привести к изменению свойств спермы. Важно помнить, что такие изменения могут быть временными, но если они сохраняются длительное время, рекомендуется обратиться к специалисту для диагностики и возможного лечения. Врач может провести необходимые анализы и дать рекомендации по улучшению состояния.
https://youtube.com/watch?v=F4Ie-hLRLVA
Заболевания репродуктивных органов
Патологическая природа появления прозрачного эякулята может быть заподозрена, если сперма неожиданно стала жидкой и бесцветной. Прозрачность указывает на отсутствие сперматозоидов, что делает такой эякулят, скорее всего, недееспособным. Патологии могут быть как врожденными, так и приобретенными. Аномалии в строении репродуктивной системы могут формироваться еще в утробе матери, и подросток может не подозревать о наличии проблемы до наступления половой зрелости.
Приобретенные заболевания, которые могут привести к образованию прозрачной спермы, часто вызваны бактериальной инфекцией. За 1-2 недели до изменения цвета спермы мужчина может заметить, что эякулят стал желтым или зеленым. Также могут образовываться комочки из-за слипания сперматозоидов. По мере прогрессирования болезни эякулят постепенно теряет цвет.
Механизмы, способствующие образованию прозрачной спермы:
- Нарушение сперматогенеза. Проблема возникает непосредственно в яичках. Производство сперматозоидов может нарушаться из-за заболеваний, связанных с трофикой органа, деградацией тканей или воспалительными процессами.
- Экскреторная азооспермия. В этом случае производство сперматозоидов не нарушено, однако есть проблемы с выведением спермы. Патология может находиться в семявыводящих протоках. Иногда наблюдается выделение семенной жидкости, которая смогла просочиться, но в небольшом количестве.
Нормальный объем эякулята составляет 2-4 мл. Превышение этого показателя может свидетельствовать о наличии острого или хронического воспалительного процесса, например, при простатите. Семенная жидкость становится более жидкой, как вода, а ее объем может увеличиваться до 10 мл. Это происходит из-за участия предстательной железы в образовании семенной жидкости, и воспаление органа приводит к повышенной выделительной активности.
Заболевания, способствующие появлению прозрачной спермы:
| Происхождение | Возможные патологии |
|---|---|
| Врожденные патологии | * монорхизм или полное отсутствие яичек; * фимоз; * синехии семявыводящих протоков; * варикоцеле; * эписпадии |
| Бактериальная инфекция | * сифилис; * гонорея; * мягкий шанкр; * эпидидимит; * хламидиоз; * кандидоз |
| Травмы | * нарушение микроциркуляции крови из-за травмы; * разрыв яичка или отрыв семенного канала; * перекрут яичка |
| Эндокринные расстройства | * сахарный диабет; * дефицит тестостерона; * гипотиреоз — гормональное бесплодие; * рассеянный склероз |
Не стоит забывать о генетической предрасположенности к появлению прозрачной спермы. Эта ситуация может наблюдаться при синдроме Клайнфельтера, врожденном заболевании, при котором у мужчины имеется дополнительная половая хромосома. В таких случаях мужчины полностью стерильны, а их семя имеет прозрачный цвет. Выявить этот дефект с помощью стандартных лабораторных исследований не удастся.
| Причина | Объяснение | Рекомендации |
|---|---|---|
| Частая эякуляция | При частых эякуляциях организм не успевает выработать достаточное количество сперматозоидов и семенной жидкости, что приводит к снижению концентрации и разжижению эякулята. | Сократить частоту эякуляций, давая организму время на восстановление. |
| Обезвоживание | Недостаточное потребление воды может привести к снижению объема семенной жидкости, делая ее более концентрированной, но при этом менее вязкой и прозрачной. | Увеличить потребление чистой воды в течение дня. |
| Недостаток питательных веществ | Дефицит цинка, селена и других микроэлементов, необходимых для сперматогенеза, может влиять на качество спермы, включая ее консистенцию. | Сбалансировать рацион питания, включить продукты, богатые цинком (морепродукты, орехи, мясо) и селеном (бразильский орех, рыба). Возможно, рассмотреть прием витаминно-минеральных комплексов после консультации с врачом. |
| Стресс и усталость | Хронический стресс и переутомление могут негативно влиять на гормональный фон и общее состояние организма, что отражается на качестве спермы. | Управлять стрессом (медитация, йога, хобби), обеспечить достаточный сон и отдых. |
| Некоторые лекарства | Некоторые препараты (например, антибиотики, гормональные препараты) могут временно влиять на качество спермы. | Проконсультироваться с врачом о возможных побочных эффектах принимаемых лекарств. Не прекращать прием препаратов без указания врача. |
| Инфекции мочеполовой системы | Воспалительные процессы в предстательной железе, уретре или других органах мочеполовой системы могут изменять состав и консистенцию спермы. | Обратиться к урологу для диагностики и лечения возможных инфекций. |
| Гормональные нарушения | Дисбаланс гормонов, таких как тестостерон, может влиять на продукцию спермы и ее характеристики. | Пройти обследование у эндокринолога или уролога для оценки гормонального статуса. |
| Варикоцеле | Расширение вен семенного канатика может приводить к повышению температуры в мошонке, что негативно сказывается на сперматогенезе и качестве спермы. | Обратиться к урологу для диагностики и обсуждения возможных методов лечения. |
| Воздействие токсинов | Курение, употребление алкоголя, воздействие некоторых химических веществ могут ухудшать качество спермы. | Отказаться от вредных привычек, избегать контакта с токсичными веществами. |
| Возраст | С возрастом качество спермы может естественным образом изменяться, включая ее консистенцию. | Поддерживать здоровый образ жизни, регулярно проходить медицинские осмотры. |
| Идиопатическая олигоспермия | В некоторых случаях причина снижения качества спермы остается невыясненной. | Консультация с репродуктологом для дальнейшей диагностики и обсуждения возможных вариантов. |
Постановка диагноза
При возникновении проблем рекомендуется обратиться за консультацией к андрологу или урологу. Процесс диагностики состоит из двух основных этапов: сбор анамнеза и лабораторные исследования. Лабораторные анализы необходимы для подтверждения поставленного диагноза. Врач может назначить следующие методы диагностики:
- Бактериальный посев — для выявления патогенных бактерий.
- УЗИ и рентгенологическое обследование паховой области — для оценки состояния тканей органов репродуктивной системы.
- Спермограмма — для определения жизнеспособности и активности сперматозоидов.
В более сложных случаях может быть назначена компьютерная томография, которая помогает обнаружить онкологические процессы в тканях.
Некоторые мужчины могут путать выделения, возникающие при возбуждении, с семенной жидкостью. Однако природный мужской лубрикант не является спермой, но играет важную роль в обеспечении свободного продвижения эякулята по уретре. Объем выделяемой смазки может быть значительным, а ее прозрачный цвет и текучая консистенция считаются нормальными для этого типа жидкости.
https://youtube.com/watch?v=9VNDiStaX8E
Лечение
Качество эякулята в значительной степени определяется образом жизни, даже если основная причина проблемы связана с заболеванием. Рекомендуется по возможности избегать переутомления и стрессовых ситуаций, а также отказаться от курения и употребления алкоголя. Мужчинам, ведущим малоподвижный образ жизни, стоит делать 25-минутные перерывы на зарядку каждый час сидения. Это поможет предотвратить застойные явления в органах малого таза и обеспечит их нормальное кровоснабжение.
Основное лечение будет зависеть от выявленной патологии. Важно обратиться к врачу как можно раньше, так как существует высокий риск развития бесплодия.
Лечение прозрачной спермы включает:
- антибактериальную терапию — эффективна в случаях, когда обесцвечивание эякулята вызвано бактериями;
- противогрибковые препараты — применяются при кандидозах;
- гормональную терапию — назначают при нарушениях в эндокринной системе;
- хирургическое вмешательство — необходимо при наличии врожденных аномалий или травм.
Во время лечения врачи рекомендуют принимать витамины группы В3, В6, В12, а также С и Е. Полезно также включить в рацион микроэлементы в таблетках: цинк, железо и магний. Необходимо увеличить потребление белковой пищи животного происхождения.
Источники
- Научная электронная библиотека. Монографии, выпущенные издательством Российской Академии Естествознания. 1.4. Физиология спермы.
- Протокол проведения спермиологического анализа. Научная статья по специальности «Фундаментальная медицина» автор Брагина Елизавета Ефимовна. 2014 год.
- ВЛИЯНИЕ УСЛОВНО-ПАТОГЕННОЙ МИКРОФЛОРЫ ПРИ ХРОНИЧЕСКОМ ПРОСТАТИТЕ, СВЯЗАННОМ С CHLAMYDIA TRACHOMATIS. Попков В.М., Чураков А.А., Долгов А.Б., Дерюгина Л.А. Журнал Фундаментальные исследования. – 2014. – № 10 (часть 7) – С. 1386-1388.
- СРАВНЕНИЕ МЕТОДИК ВЫДЕЛЕНИЯ СПЕРМАТОЗОИДОВ ИЗ ЧЕЛОВЕЧЕСКОЙ СПЕРМЫ. Плосконос М.В. Журнал Международный журнал прикладных и фундаментальных исследований. – 2016. – № 2 (часть 1) – С. 41-43. Дата публикации 22.02.2016.
- Современные взгляды на влияние инфекций, передающихся половым путем, на развитие урогенитальной патологии у мужчин. РМЖ. №2 от 30.05.2019, стр. 32-38. Автор: Винник Ю.Ю.
- Предиабет как междисциплинарная проблема: настало время действовать. Необходимо остановить путь пациента от ожирения к предиабету, а затем к диабету 2 типа. 2022-02-07.
- Применение бесшовного метода циркумцизии в хирургическом лечении фимоза у детей и подростков. Тема диссертации и автореферата по ВАК РФ 14.00.27, кандидат медицинских наук Мохаммад, Башир.
- Инфекции мочевыводящих путей. Современные подходы врача-уролога. РМЖ. №11 от 24.12.2019, стр. 21-26. Авторы: Зайцев А.В., Ширяев А.А., Ким Ю.А., Сазонова Н.А., Прилепская Е.А., Васильев А.О., Пушкарь Д.Ю.
https://youtube.com/watch?v=3ZtGAXVcH70
Влияние образа жизни на качество спермы
Качество спермы является важным показателем репродуктивного здоровья мужчин, и на него влияет множество факторов, включая образ жизни. Современные исследования показывают, что различные аспекты повседневной жизни могут существенно изменять консистенцию и прозрачность спермы.
Одним из ключевых факторов является питание. Неправильный рацион, богатый трансжирами, сахаром и обработанными продуктами, может негативно сказаться на качестве спермы. Исследования показывают, что диета, богатая антиоксидантами, витаминами (особенно витамином C и E), а также минералами, такими как цинк и селен, способствует улучшению качества спермы. Употребление свежих фруктов, овощей, орехов и рыбы может помочь поддерживать оптимальное состояние сперматозоидов.
Физическая активность также играет важную роль. Регулярные физические упражнения способствуют улучшению кровообращения и обмена веществ, что, в свою очередь, может положительно сказаться на качестве спермы. Однако чрезмерные физические нагрузки, особенно в сочетании с недостаточным восстановлением, могут привести к обратному эффекту, снижая уровень тестостерона и ухудшая качество спермы.
Курение и употребление алкоголя являются еще одними значительными факторами, влияющими на качество спермы. Никотин и алкоголь могут вызывать окислительный стресс, что приводит к повреждению сперматозоидов и изменению их структуры. Исследования показывают, что мужчины, которые курят или злоупотребляют алкоголем, чаще сталкиваются с проблемами, связанными с фертильностью.
Стресс и психоэмоциональное состояние также оказывают влияние на качество спермы. Хронический стресс может привести к повышению уровня кортизола, что негативно сказывается на гормональном фоне и, соответственно, на производстве спермы. Практики, направленные на снижение стресса, такие как медитация, йога и физические упражнения, могут помочь улучшить общее состояние здоровья и качество спермы.
Наконец, важно учитывать влияние окружающей среды. Загрязнение воздуха, воздействие химических веществ и радиации могут негативно сказаться на репродуктивной функции. Мужчины, работающие в условиях повышенного риска (например, на химических заводах), должны принимать меры предосторожности, чтобы минимизировать воздействие вредных факторов.
Таким образом, образ жизни играет критическую роль в поддержании здоровья спермы. Правильное питание, регулярные физические нагрузки, отказ от вредных привычек и управление стрессом могут существенно улучшить качество спермы и, следовательно, повысить шансы на успешное зачатие.
Питание и его роль в изменении консистенции спермы
Питание играет ключевую роль в формировании качества и консистенции спермы. Состав пищи, которую употребляет мужчина, напрямую влияет на здоровье его репродуктивной системы. Разнообразные продукты могут как улучшать, так и ухудшать качество спермы, включая её консистенцию.
Одним из основных факторов, влияющих на консистенцию спермы, является уровень гидратации организма. Недостаток жидкости может привести к сгущению спермы, в то время как достаточное потребление воды способствует её разжижению. Вода помогает поддерживать оптимальный уровень жидкости в организме, что, в свою очередь, влияет на состав семенной жидкости.
Кроме того, определённые продукты могут оказывать влияние на консистенцию спермы. Например, употребление большого количества жирной пищи, особенно трансжиров, может негативно сказаться на качестве спермы. Напротив, продукты, богатые омега-3 жирными кислотами, такие как рыба, орехи и семена, могут улучшить её качество и консистенцию.
Витамины и минералы также играют важную роль в поддержании здоровья спермы. Витамин C, содержащийся в цитрусовых, ягодах и зелени, помогает защищать сперматозоиды от окислительного стресса и может способствовать улучшению их подвижности. Витамин E, содержащийся в орехах и растительных маслах, также способствует улучшению качества спермы. Цинк, который можно найти в мясе, морепродуктах и бобовых, важен для производства тестостерона и поддержания здоровья сперматозоидов.
Некоторые исследования показывают, что диеты, богатые антиоксидантами, могут также способствовать улучшению качества спермы. Антиоксиданты помогают бороться с окислительным стрессом, который может негативно влиять на сперматозоиды и их способность к оплодотворению. Продукты, богатые антиоксидантами, включают фрукты, овощи, зелёный чай и тёмный шоколад.
Важно отметить, что изменения в консистенции спермы могут быть временными и зависеть от различных факторов, включая стресс, физическую активность и общее состояние здоровья. Поэтому для поддержания здоровья репродуктивной системы рекомендуется следить за своим питанием, избегать вредных привычек и вести активный образ жизни.
Психологические факторы и их влияние на репродуктивное здоровье
Психологические факторы играют значительную роль в репродуктивном здоровье мужчин, и их влияние на качество спермы не следует недооценивать. Стресс, тревога и депрессия могут оказывать негативное воздействие на гормональный баланс, что, в свою очередь, может привести к изменениям в составе и консистенции спермы.
Когда мужчина испытывает хронический стресс, уровень кортизола, гормона стресса, повышается. Это может привести к снижению уровня тестостерона, который отвечает за производство спермы. Низкий уровень тестостерона может вызвать изменения в физическом состоянии спермы, включая ее консистенцию. В результате сперма может стать более жидкой и прозрачной, что может быть признаком снижения ее качества.
Кроме того, психологические проблемы могут влиять на сексуальную функцию. Например, тревога и депрессия могут привести к снижению либидо и эректильной дисфункции, что также может сказаться на качестве спермы. Неправильное функционирование репродуктивной системы может привести к тому, что сперма будет производиться в меньших количествах или с измененной консистенцией.
Важно отметить, что психологические факторы могут также влиять на образ жизни мужчины. Например, стресс может привести к плохим привычкам, таким как курение, злоупотребление алкоголем или неправильное питание, что также негативно сказывается на репродуктивном здоровье. Эти факторы могут усугублять проблему, создавая замкнутый круг, в котором психологическое состояние и физическое здоровье взаимно влияют друг на друга.
Для улучшения репродуктивного здоровья важно учитывать не только физические аспекты, но и психологические. Психотерапия, занятия спортом, медитация и другие методы управления стрессом могут помочь улучшить общее состояние здоровья и, как следствие, качество спермы. Поддержка со стороны партнеров и близких также играет важную роль в преодолении психологических трудностей, что может положительно сказаться на репродуктивной функции.